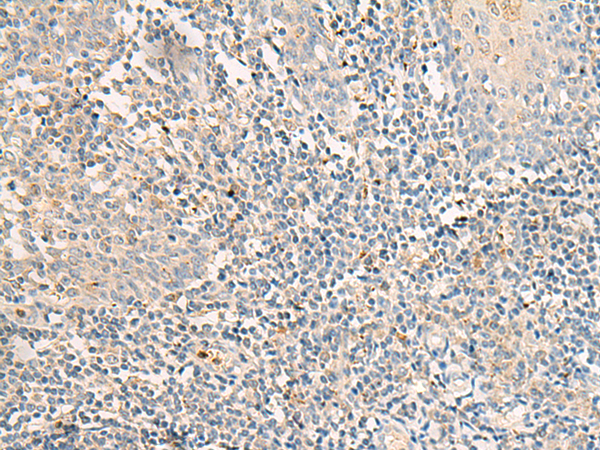

-
分类: 科研抗体货号: P06610别名: ENA; MENA; NDPP1应用: IHC反应种属: Human, Mouse
-
分类: 科研抗体货号: P06577别名: PIF79; GMEB-2; P79PIF应用: IHC反应种属: Human, Mouse, Rat
-
分类: 科研抗体货号: P06644别名: RAIG3; RAIG-3应用: IHC反应种属: Human, Mouse
-
分类: 科研抗体货号: P06608别名: RP78; P114-RhoGEF应用: IHC反应种属: Human
-
分类: 科研抗体货号: P06575别名: GPIV; GPVI; BDPLT11应用: WB,IHC反应种属: Human
-
分类: 科研抗体货号: P06640别名: ITR应用: IHC反应种属: Human, Mouse
-
分类: 科研抗体货号: P06607别名: MTGM; MTGMP; C20orf52; bA353C18.2应用: WB,IHC反应种属: Human, Mouse
-
分类: 科研抗体货号: P06574别名: EARS; EPRS; PARS; QARS; QPRS; HLD15; PIG32; GLUPRORS应用: IHC反应种属: Human, Mouse
-
分类: 科研抗体货号: P06638别名: HB-954应用: IHC反应种属: Human, Mouse, Rat
-
分类: 科研抗体货号: P06606别名:应用: IHC反应种属: Human, Mouse

鄂公网安备42018502007531号
鄂公网安备42018502007531号

